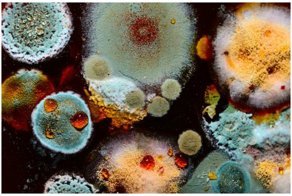
Очень опасная и очень красивая - все краски тлена

268361
6
Я думаю каждому хоть раз, да рисовали йодную сеточку при кашле, или простуде. А вот вы хоть раз задумывались, как она работает? Что же это за магия-то такая, которая лечит от тысячи болезней?
Йод обладает местно-раздражающим, активизирующим кровообращение и противовоспалительным действием. Именно благодаря этим свойствам им стали рисовать йодные сетки.
Йодные сетки наносят чаще всего на спину или грудь заболевшего. Йод стимулирует приток крови к "больной" зоне, и благодаря циркуляции крови в этой зоне повышается температура. Проще говоря - йодная сетка греет.
Область применения просто поражает:
Йодные сетки наносят чаще всего на спину или грудь заболевшего. Йод стимулирует приток крови к "больной" зоне, и благодаря циркуляции крови в этой зоне повышается температура. Проще говоря - йодная сетка греет.
Область применения просто поражает:
С помощью йода можно определить его нехватку в организме
Всё просто. Наносится йодная сетка на нежный участок кожи, и ждём, пока впитается. Если уровень йода в организме нормальный - сетка продержится сутки, если нет - то 6-7 часов.
Если сетка исчезла быстро, то нужно подкорректировать уровень йода, питаясь продуктами с высоким его содержанием.
Если сетка исчезла быстро, то нужно подкорректировать уровень йода, питаясь продуктами с высоким его содержанием.
×
Кашель
При кашле йодную сетку стоит наносить на спину в области легких, и на грудь, избегая области сердца. Процедуру повторить 3-4 раза, один раз в день .
Варикоз
При поражении вен йод нужно наносить на проблемные участки кожи, но не чаще двух раз в неделю на протяжении двух месяцев.
Ушибы, болезни позвоночника
При синяках, ушибах и растяжениях йод следует наносить ежедневно, небольшими количествами на поражённую кожу.
При радикулитах и болях в спине йод наносят по вертикали над внутренней частью лопаток, параллельно позвоночнику.
При радикулитах и болях в спине йод наносят по вертикали над внутренней частью лопаток, параллельно позвоночнику.
Противопоказания
Всё-таки йод - это лекарство, и пользоваться им стоит с осторожностью. Нельзя его применять:
- детям до 3-х лет, так как у них ещё не сформированы функции щитовидной железы,
- при повышенной температуре,
- осторожностью стоит его применять беременным...
- детям до 3-х лет, так как у них ещё не сформированы функции щитовидной железы,
- при повышенной температуре,
- осторожностью стоит его применять беременным...
Будьте здоровы!
Источник:
Ссылки по теме:
- Британец обнаружил странные точки на стопе, и его жестоко затроллили в сети
- Очень опасная и очень красивая - все краски тлена
- Почему йод наносят именно сеточкой
- 12 печальных раз, которых аллергия застала врасплох и кардинально изменила лица
- Пластический хирург "украсил" свою пациентку, введя ей под кожу цемент
реклама

Всем рекомендую!
Гамма-излучение, которое образуется при радиоактивном распаде атома йода, проникает сквозь организм человека (имеет большой пробег, но маленькую энергию). Таким образом, оно не воздействует на клетки организма. Но может быть использовано в диагностических целях. Так можно определить, где еще в организме накопился йод с помощью специальной гамма-камеры, которая регистрирует такое излучение. Если такие очаги есть, то можно думать о существовании метастазов рака ЩЗ.
Йод обладает способностью к самопроизвольному распаду атома. Период полураспада составляет 8 суток. При этом образуется нейтральный атом ксенона, квант гамма-излучения и бета частица (электрон). Терапевтическое действие осуществляется именно благодаря бета частицам. Такие частицы имеют очень высокую скорость движения, но маленький пробег в тканях (до 2 мм). Таким образом, они проникают в биологические ткани (клетки ЩЗ) и разрушают клетку (цитотоксическое действие).
Источник:
Писец. Дитя ЕГЭ.
нет уж, как все обычные дети 90-х, я нюхала паркетный лак
все нюхали клей, но я была приличной девочкой, рисовала, расписывала деревянные доски, потом их покрывали лаком, вот и нанюхалась однажды до глюков
Эх-х, налейте, выпийте и всё пройдёт...
Официально показали трансмутацию элементов в живых клетках.
Если не ошибаюсь, то работали с клетками курицы.